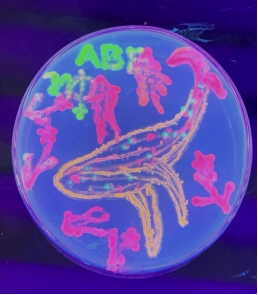

2023年1月,哈尔滨师范大学生命科学学院(以下简称“哈师大生科院”)与清华大学-北京大学生命科学联合中心合作,开展了第三届ABE培训活动。整个活动由生命中心负责开发和制定教学计划、提供师资,哈师大生科院提供培训实验场地、设施设备等,并指派老师全程协助。活动选拔了我省各重点中学如哈三中、师大附中、德强中学、哈九中和大庆实验等的30名优秀高中生参加了为期3天的实验体验活动。
1月11日上午,开班仪式在哈尔滨师范大学理工三号楼生科院423多媒体教室举行,清华大学张贵友教授、江轶老师,北京大学陈峰研究员,哈师大附中张庆岭、李春凤,生科院院长刘妍、副院长潘旭明等老师出席了开班仪式。开班仪式由潘旭明主持。

哈师大生科院刘妍院长首先对来自清华大学—北京大学生命科学联合中心的老师和省内前来参加培训的学生们表示热烈欢迎,并希望同学们在老师的指导下完成实验操作,以这三天的实验体验活动为契机,激发科学兴趣,永攀高峰,并预祝培训圆满成功。
ABE中国大陆站点负责人、清华大学-北京大学生命科学联合中心办公室主任江轶老师对本次活动进行了简要介绍和知识点讲解,强调从事生命科学研究要有前瞻意识,着眼于未来的药物开发和科技进展,并对参加活动的同学表示了肯定和鼓励。
黑龙江省生物奥赛教练张庆岭老师发言,介绍几天的培训安排,并希望同学们能够珍惜各方机构为大家创造的机会,要有学习热情,培养创新意识,感受实验之美,体会属于生命科学的独特魅力。

全球性中学生科普项目Amgen Biotech Experience(以下简称“ABE”)是一项旨在培养新一代科学家和创新者的科普活动,通过邀请中学生进入实验室体验最新的生物技术和科学发现,激发学生们对生命科学的热爱。清华大学-北京大学生命科学联合中心(以下简称“生命中心”)作为ABE中国大陆承办方,于2021年将ABE创新科学教育项目引入中国。
本次ABE活动培训活动分为三个部分。
第一部分由清华大学生科院崔樱子博士讲解并带领同学们完成包括质粒提取、核酸的电泳检测、重组表达载体的构建、大肠杆菌的转化、利用PCR技术进行阳性克隆的检测等实验,并对蛋白质分离纯化的相关内容给同学们进行了拓展和延伸。让高中课本上那些深奥、抽象、微观的内容清晰的展现在同学们眼前。
第二部分,崔樱子博士还为同学们带来了生命科学前沿的讲座,结合清华大学的最新研究,对新型冠状病毒及新冠病毒疫苗的研发、应用进行了详细的解读。李瑶曦老师为同学们带来了液液相分离的相关研究前沿科学讲座,这些讲座让同学们感受到了前沿科学的魅力。
第三部分,北大医学部的陈峰研究员结合自身的求学经历和研究背景给同学们做了讲座,让同学们感受到了一位科学工作者的成长经历,他强调兴趣是最好的老师,遵从自己的内心,希望通过本次体验活动能将研究生命科学的种子种在同学们的心里,给同学们带来了巨大的鼓舞。 三天的时间,同学们有真实的体验、思想上的碰撞、实验成功时的欣喜,也有实验出现意外时的顽强,真切的感受到了科学研究的魅力。


1月13日的结业式上,清华大学现代生命科学实验教学中心主任张贵友教授、哈尔滨师范大学生科院院长刘妍分别在闭幕式上进行了总结发言,对参加活动的同学表示肯定和鼓励,希望同学们能全面发展,不怕挫折,投身生命科学研究领域,为探索未知的生命世界贡献力量。
本次ABE培训项目的顺利开展,既是黑龙江省中学生科普教育首次与国际中学生科普教育接轨,也是清华大学—北京大学生命科学联合中心与哈尔滨师范大学生科院的一次重要合作,有助于激发学生们的科学兴趣,培养创新能力,树立科学志向;提升我校服务基础教育及培养人才的能力,推进黑龙江省生物科学“英才计划”的实施。
